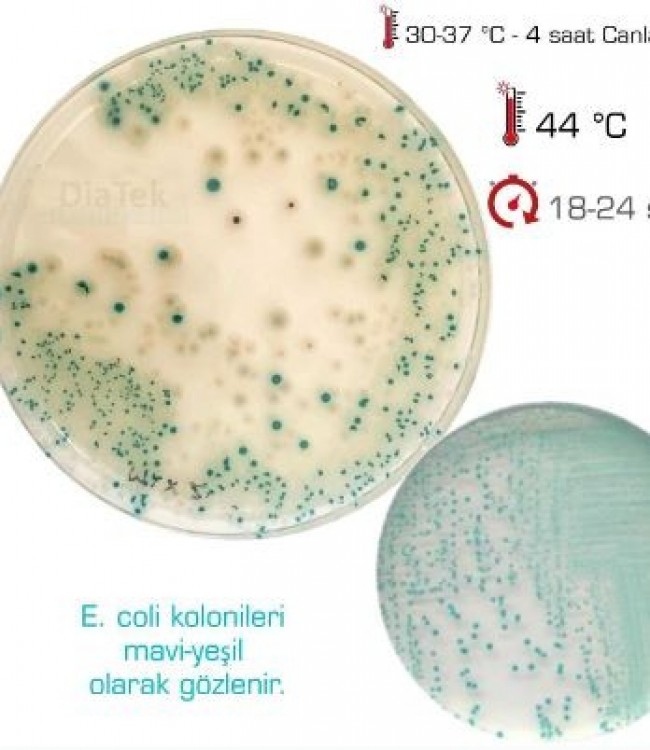

TBX Chromogenic Agar
TBX Chromogenic Agar
Mikrobiyolojik analizlerde koliform grup bakteriler ve Escherichia
coli aranması ve sayılması için selektif katı besiyeri olarak kullanılmaktadır
E. coli kolonileri mavi—yeşil renkli olarak görülür. Refakatçi flora safra tuzlarıyla baskılanır.
İnkübasyonun 44 C'da yapılması da refakatçi florayı baskılayan bir başka etkendir.
İşlem görmüş gıdalarda E. coli analizi için önce 30-37 C’da 4 saat canlandırma işleminden sonar inkübasyon sıcaklığının 44 C çıkartılması ve 18-20 saat inkübasyon yapılması önerilmektedir.